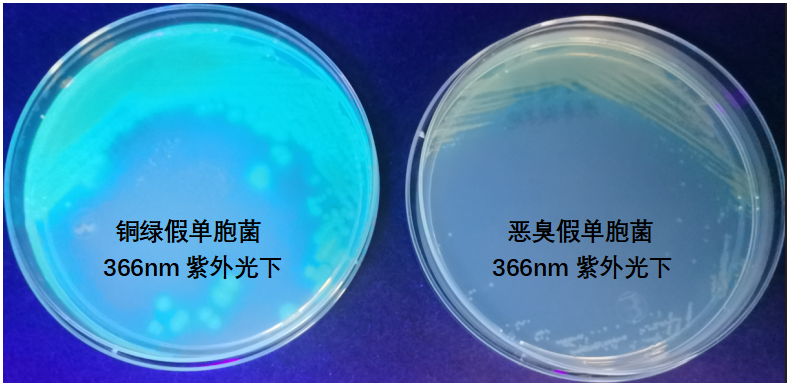
天然礦泉水檢測中的新角色--惡臭假單胞菌

惡臭假單胞菌(Pseudomonas putida)屬于假單胞菌屬,為革蘭氏陰性桿菌。有些菌株為卵圓形,單端叢毛菌,運動活潑。惡臭假單胞為專性需氧菌,廣泛存在于土壤和水中。
在GB 8538-2022《食品安全國家標準 飲用天然礦泉水檢驗方法》銅綠假單胞檢測項目中,要求定期使用惡臭假單胞菌作為陰性對照菌對整個檢驗過程進行質量控制。
今天我們就通過實驗詳細介紹一下惡臭假單胞的菌株活化及生化特性等。
一、惡臭假單胞菌菌株活化
菌株活化一定要選擇合適的培養(yǎng)條件才能夠保證微生物的生長?!恫芗毦b定手冊》中表明惡臭假單胞菌最適生長溫度為25℃-30℃。ATCC(美國菌種保藏中心)給出的菌株活化說明中,培養(yǎng)溫度為30℃;CICC(中國工業(yè)微生物菌種保藏中心)菌種說明中要求培養(yǎng)溫度為28℃。


我們將菌株接種到營養(yǎng)瓊脂平板和BHI(腦心浸液培養(yǎng)基)中分別置于36℃和28℃培養(yǎng)箱中培養(yǎng)24h。經實驗發(fā)現,惡臭假單胞菌在36℃也可以生長,但比28℃生長弱一些。所以在菌株活化時,為保證菌株良好生長建議25℃-30℃進行培養(yǎng)。

二、惡臭假單胞菌的生物學特性
在GB 8538-2022《食品安全國家標準 飲用天然礦泉水檢驗方法》銅綠假單胞檢測項目中,惡臭假單胞菌為陰性對照菌,銅綠假單胞菌為陽性對照菌。那么惡臭假單胞菌生物學特性是什么?與銅綠假單胞菌又有何區(qū)別?我們通過實驗現象來進行了解。
1)假單胞CN瓊脂
將活化好的菌株接種假單胞CN瓊脂,36℃培養(yǎng)24h。平板上銅綠假單胞為藍綠色菌落,而惡臭假單胞為無色菌落。將平板置于366nm紫外燈下觀察熒光,銅綠假單胞有熒光,惡臭假單胞無明顯熒光。

2)綠膿菌素測試
將菌株接種到綠膿菌素測定培養(yǎng)基上,36℃±1℃培養(yǎng)24h±2h,加入三氯甲烷3mL~5mL,可搗碎培養(yǎng)基并充分振蕩使培養(yǎng)物中的綠膿菌素溶解于三氯甲烷,待三氯甲烷提取液呈藍色時,用吸管將三氯甲烷移到另一試管中,并加入1mol/L的鹽酸1mL,振蕩后,靜置片刻。如上層鹽酸液內出現粉紅色到紫紅色時為陽性。
銅綠假單胞菌綠膿菌素實驗為陽性,惡臭假單胞菌為陰性。

3)產胺實驗
將菌株接種至乙酰胺液體培養(yǎng)基中,在36℃±1℃下培養(yǎng)20h~24h。然后向每支試管培養(yǎng)物加入1滴~2滴鈉氏試劑,10s內檢查各試管的顏色變化,如表現出從黃色到磚紅色的顏色變化,則為陽性結果,否則為陰性。
銅綠假單胞菌產胺實驗為陽性,惡臭假單胞菌為陰性。

4)42℃生長實驗
將菌株接種營養(yǎng)瓊脂平板上或者42℃生長試驗生化管中,42℃±1℃ 培養(yǎng)24h~48h,能生長為陽性結果,否則為陰性。
銅綠假單胞菌42℃生長實驗為陽性,惡臭假單胞為陰性。

5)氧化酶實驗
?。驳巍车涡迈r配制的氧化酶試劑滴到放于平皿里的潔凈濾紙上。?將菌株純培養(yǎng)物涂布在預備好的濾紙上。在10s內顯深藍紫色的視為陽性反應。?
銅綠假單胞菌和惡臭假單胞菌氧化酶實驗均為陽性。

6)金氏B培養(yǎng)基產熒光實驗
將菌株接種于金氏B培養(yǎng)基36℃±1℃恒溫箱培養(yǎng)1d~5d。每天需取出在紫外燈下檢查其是否產生熒光,將5d內產生熒光的菌落記錄為陽性。
銅綠假單胞菌產生熒光為陽性,惡臭假單胞菌不產熒光為陰性。

綜合以上實驗結果,銅綠假單胞菌和惡臭假單胞菌在培養(yǎng)基上的菌落形態(tài)以及主要生化反應結果匯總如下:

參考文獻:
1、GB 8538-2022《食品安全國家標準 飲用天然礦泉水檢驗方法》
2、《伯杰細菌鑒定手冊》【M】,科學出版社,布坎南(R.E.Buchanan)等編,1984
點擊下方鏈接,查看GB 8538-2022檢測產品列表
GB 8538-2022檢測產品列表